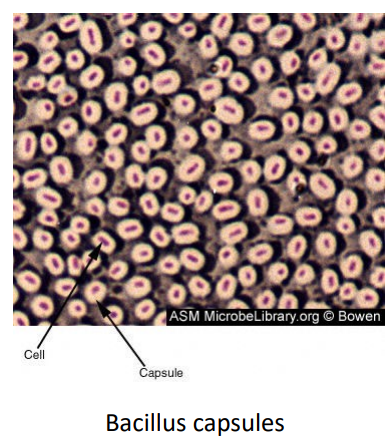

What are the differences in genetic structure between eukaryotes and prokaryotes when it comes to: • Nucleus • Shape of DNA • Arrangement of DNA • Proteins/ribosomes
Eukaryotes
• Has a true nucleus, which is bound by a double membrane.
• Linear DNA
• DNA rapped around histone protein to form chromosomes
• Large complex 80S ribosome with many types of Mrna protein
•
Prokaryotes
• No nucleus, has a nucleoid (nucleus-like – region that contains DNA), no physical boundary
• Circular DNA
• DNA ‘naked’ and plasmids present
• Plasmids are small circular DNA molecules that can replicate independently of chromosomal DNA (DNA in bacteria in bacteria is still referred to as chromosome, even thought there are no chromosomes_
• Contains 70S ribosomes

Difference of structure between eukaryotes and prokaryotes in reference to:
• Organelles
• Site of aerobic respiration
• Protein formation
Eukaryotes
• Cytoplasm filled with large, complex collection of organelles, with some membrane bound organelles (nucleus, ER, Golgi etc)
• Mitochondria with cristae (folds in mitochondrion) to increase surface area for chemical reactions) are energy centers
• Transcription requires formation of Mrna via transcription and the movement of the mrna from the nucleus to the cytoplasm for translation
Prokaryotes
• No membrane bound organelles independent of plasma membrane
• Mesosomes are used in aerobic respiration – folds in the bacterial membrane that can invaginate, and pinch off to become a free organelle in the cell. Also used to increase surface area for aerobic respiration.
• Transcription and translation occur simultaneously

What are the main 6 structures of bacteria?
- Capsule
- Pili (fimbria)
- Flagella
- Spores
- Slime
- Cell wall

What is the bacterial capsule made from? LPD
What is its function?
- The bacterial capsid is a loose polysaccharide structure
- It protects bacterium from phagocytosis by immune system cells
- Protects the cell from desiccation (drying out)
What are pili/fimbriae mean?
What are they made from? opp
What are they used for by bacteria?
How are they treated by the immune system?
Are they on all bacteria?
What might they contain?
- Pilus/fimbria (singular) means hair/thread
- They are composed of oligomeric pilin proteins
- They are the appendage used for bacteria conjugation by forming a bridge to enable the transfer of plasmids between bacteria
- They facilitate bacterial attachment to host cells.
- They are highly antigenic, meaning they elicit a strong immune response
- Pili/fimbriae are not on all bacteria
- They may contain lectins, which recognize oligosaccharide units on host cells, which play a key role in pathogen recognition in humans

What does flagella mean?
What are they used for?
Where are they found?
How do they work?
What are they made from? …lin
How big are they?
Why is movement important to bacteria?
What is an example of bacteria with flagella?
What are the different types of flagella? …trichous
- Flagellum (singular) means whip
- They are the organs of locomotion, and are only found on motile (moving) bacterium
- They are driven by a rotary engine at the anchor points on the inner cell membrane
- Flagella are composed of flaggelin protein
- They are 20nm-thick hollow tubes
- Movement allows bacteria to move from area of low nutrient density to areas of high nutrient density
- It can also allow organisms to penetrate host mucous
- E.Coli has flagella

Are spores in every bacterium?
How do they form? => hives
What are they adapted for?
How are they adapted for this?
What is a common disease formed by sporing bacteria?
- Spores are only found in some bacterium
- They are metabolically inert form, which form as a stress response triggered by adverse environmental conditions, such as dryness, cold, and radiation
- They are adapted for long-term survival and allow regrowth under suitable conditions
- Spores have hard, multi-layered coats, making them difficult to kill
- Botulism – Clostridium botulinum

What is slime made of?
What is it secreted by?
What are its functions?
- Slime is a polysaccharide material
- It is secreted by some bacteria growing in biofilms
- Slime protects bacteria against immune attack
- It also offers protection against eradication by anti-biotics.

How do biofilms form in the body?
What is it made of?
How does this protect bacteria from immune attacks?
is it detectable
How does this protect bacteria from anti-biotics?
Where is a biofilm present?
- When bacteria stop being planktonic (moving) and become stationary in the body, they become susceptible to host attack.
- For protection, they produce a biofilm layer on top of themselves out of a sticky polysaccharide material called slime, some free DNA, and proteins
- The bacteria are now free to replicate, and form into a city
- The sticky surface makes the biofilm antigen poor, so it is not easily detectable by the immune system
- When it is detected, it is too big to be engulfed by phagocytes.
- A layer of immune cells is placed on top of the biofilm, but the bacteria can still grow
- Anti-biotics can’t penetrate the biofilm, so they must fuse through, and many cant.
- A biofilm is present on our teeth before we brush them.

What is gram staining?
What is it used for?
What are the 2 classifications of bacterium based on this test?
What color do they turn?
What do they contain?
- Gram staining is a lab test that is able to differentiate bacterial species based on chemical and physical properties of their cell walls.
- Bacterium can either be Gram positive (+purple), or Gram negative (-pink)
- Gram positive bacterium have a simpler cell wall structure
- It consists of 2 layers: Thick PGN (peptidoglycan) layer containing LTA (lipoteichoic acid), and a cytoplasmic membrane
- Gram negative bacterium have a more complex cell wall.
- It consists of 3 layers: outer membrane containing LPS (lipopolysaccharide), a thin PGN layer (in periplasmic space), and a cytoplasmic membrane.

What are the 4 steps of Gram staining?
Sure! Here’s a simpler explanation of the Gram staining process:
- Primary Stain (Crystal Violet): This dye stains all bacteria purple.
- Trapping Agent (Gram’s Iodine): This acts like a glue. It binds to the crystal violet dye, forming a larger complex (called CVI) that stays in the bacteria. Since this complex is bigger, it doesn’t easily wash out.
- Decolorization (Alcohol/Acetone): This step removes the outer layer of Gram-negative bacteria and interacts with the lipids in their cell walls:
- Gram-positive bacteria: The thick cell wall traps the purple complex, so they stay purple.
- Gram-negative bacteria: They lose their outer layer and have a thin cell wall, so the purple complex washes away.
- Counter-stain (Safranin): This dye is used last:
- Gram-positive bacteria: Still look purple.
- Gram-negative bacteria: Turn pink or reddish because the purple stain is gone.
In summary, this process helps differentiate between Gram-positive (purple) and Gram-negative (pink) bacteria based on their cell wall structures.
Trapping agent (Gram’s iodine)
* Gram’s iodine contains a mordant, which is an ion that binds a chemical dye and holds it down.

What are the main 4 cell wall components in bacteria?
P LOL
What are each of them for?
Peptidoglycan/murein (PNG) – Forms mesh-like layer outside plasma membrane
Lipoteichoic acid (LPA) – Provides cell rigidity
Lipopolysaccharide (in gram negative bacteria only)
* Essential for function of the outer membrane
* Elicits potent immune and inflammatory host responses
* Produces endotoxins (toxin present in bacterial cell that is released when it disintegrates)
Outer membrane proteins (OMPS)
* Lipoproteins and porins present
* Not endotoxins, but do contribute to virulence (the severity or harmfulness of a disease)
How does vertical gene transfer occur in bacteria?
Is this process sexual or asexual?
How is the genome replicated in bacteria?
What can disrupt this process?
How is this vertical gene transfer advantageous?
- Vertical gene transfer occurs via binary fission, where 1 cell reproduces to make 2 identical daughter cells
- This process is asexual, as it does not involve the fusion of gametes.
- DNA replication starts at the origin and replicates in 2 directions (bidirectional replication)
- The 2 replication forks split off from the origin and meet at the bottom
- Vertical transfer is advantageous, as it means mother cells pass on survival advantages to their daughter cells, so they are more able to cope with antibiotics and immune system defenses

How do you determine the number of bacteria present after growth?
What are the 4 phases of bacterial cell growth?
What occurs at each stage?
• Bacterial cell number = 2^n, where n is the number of divisions
Lag phase
• The period of active growth in size, not number
• Bacteria prepare for reproduction by synthesising DNA and enzymes for cell division
Log/exponential phase
• Cells divide at maximum rate
• Uniform replication
• Graph line is almost straight
Stationary phase
• End of growth
• Exhaustion of nutrients
• Accumulation of inhibitory end products of metabolism or oxygen availability.
• Number of cells dying balances the number of new cells, so population stabilises
Death phase
• The number of cells dying starts to exceed the number of newly born cells, and so the number of viable cells (capable of working) starts to decline

What is horizontal gene transfer?
What are the ways it can occur?
- Horizontal gene transfer is bacterial genome recombination.
- It can occur in 3 ways
Conjugation
• One bacterium connects itself to another through the pilus
• Genes are transferred from one bacterium to the other through this tube
Transformation
• Some bacteria are capable of taking up bacteria from their environment
Transduction
• Involves the exchanging of bacterial DNA through bacteriophages (viruses that pray on bacteria)

What are some ways bacteria are classified?
FAK LIKE A GCIX
- Gram stain – positive (purple)/negative (pink)
- Cell shape – cocci, bacilli, helical, spiral
- Atmospheric preference – aerobic (oxygen), anaerobic (no oxygen), microaerophilic (little bit of oxygen)
- Key enzymes
- Fastidiousness – organism that has complex or particular nutritional requirements/environment

What are some classifications of clinically important bacteria based on gram stain and shape?
1

What are the structural components of viruses?
NECS
- Not all of these components are present in all viruses
Nucleic acid
* Double stranded or single stranded deoxyribonucleic acid or ribonucleic acid (DNA or MRNA) (4 different combinations)
Capsid
* This is the protein coat/shell
* It is composed of protein subunits called capsomeres, which consist of aggregated proteins
* There are various shapes: rod like, polyhedral, complex
Envelope
* Amorphous structure surrounding some viruses
* Composed of lipid, protein and carbohydrate
* Protects virus from desiccation from the environment (drying up)
Spikes
* Glycoprotein projections arising from envelope
* Highly antigenic (elicits a strong immune response)
* May have enzymatic, adsorption, haemagglutinin (reaction that causes clumping of red blood cells) activities

What are viruses?
How do they replicate?
What cells might they infect?
- Viruses are obligate parasites, meaning they cannot complete their life-cycle without exploiting a suitable host.
- Viruses use the hosts cellular machinery to replicate
- They produce many progenies which leave the host cell to infect other cells in the organism
- Viruses may infect animal, plant, and bacterial cells.
What are the 5 stages of viral replication?

What are protozoa?
What are their 4 classifications?
FACS
What is a common protozoal infection?
- Protozoa are single-celled eukaryotes
- They are classified as:
- Sporozoa – intracellular parasites
- Flagellates – possess tail like structures for motility
- Amoeba – use temporary cell body projections (pseudopods)
- Ciliates – move by beating multiple hair like structures (cilia)
- Malaria – plasmodium falciparum

What type of cells/organisms are fungi?
What types of organism is yeast?
What is the structure of fungi like? chitichiti
How do they grow?
How do fungi reproduce?
What can fungi be classed as?
What are fungal infections referred to as?
What is a common yeast infection?
- Fungi are eukaryotic cells that can be single or multinucleate
- They can be multicellular organisms
- Yeast is a single-celled fungal organism
- Fungi contain thick carbohydrate walls that contain chitin and glucans
- They usually grow as thread like filaments (hyphae)
- Fungi reproduce asexually by budding, and occasionally by binary fissions
- They are part of normal microbiota, as well as being pathogens
- Fungal infections = mycoses
- Candidiasis (candida albicans) is a common yeast infection.



